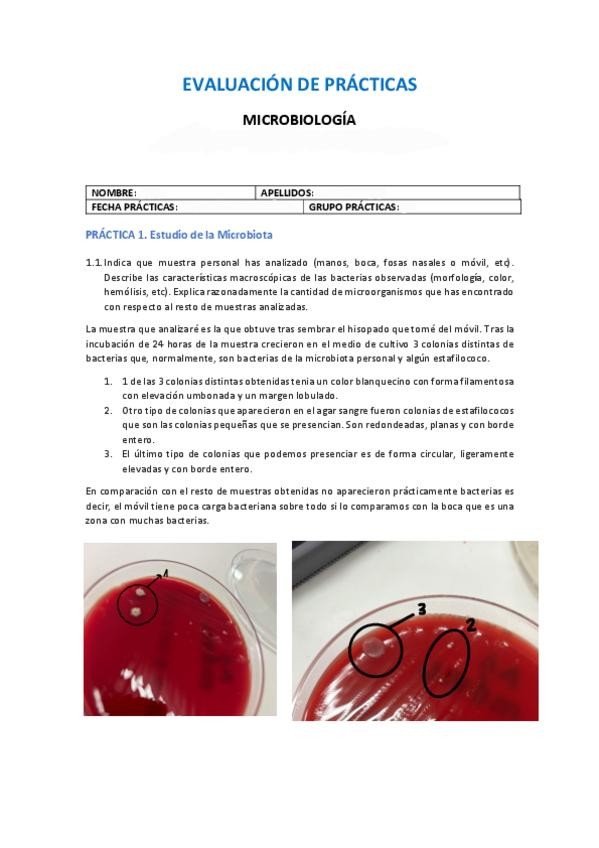

@Podouser_
26 Publicaciones
650 Interacciones
3 Seguidores
1 Siguiendo
Lista de publicaciones de Podouser_
He publicado nuevos examenes de 1º Anatomía Humana del Miembro Inferior: Examen-Anato-2024-25.pdf
apuntes
-
TEMAS 14 Y 15 (ÚLTIMOS TEMAS)
He publicado nuevos apuntes de 2º Quiropodologia: TEMAS 14 Y 15 (ÚLTIMOS TEMAS)
apuntes
-
TEMAS 10,11,12 Y 13
He publicado nuevos apuntes de 2º Quiropodologia: TEMAS 10,11,12 Y 13
He publicado nuevos apuntes de 2º Quiropodologia: TEMA-8-Y-9-GRANULOMA--INFECCIONES-BACTERIANAS.pdf
He publicado nuevos apuntes de 2º Quiropodologia: Tema-3-FISIOPATOLOGIA-CUTANEA.pdf
He publicado nuevos apuntes de 2º Quiropodologia: Tema-5-infecciones-micoticas.pdf
He publicado nuevos apuntes de 2º Quiropodologia: Tema-6-y-7-Laser-y-Lampara-de-Wood-2.pdf
He publicado nuevos apuntes de 2º Quiropodologia: Tema-4-Lesiones-dermatologicas-del-pie.pdf
He publicado nuevos apuntes de 2º Quiropodologia: Tema-2-Signos-patologicos-de-las-unas.pdf
He publicado nuevos apuntes de 2º Quiropodologia: Tema-1-Anatomia-y-fisiologia-ungueal.pdf
He publicado nuevos practicas de 1º Microbiología: Preguntas-Practicas-Laboratorio-Microbiologia.pdf
He publicado nuevos apuntes de 2º Conceptos Generales de Cirugía: cirugia-todo-menos-tema-17.pdf
He publicado nuevos apuntes de 1º Anatomía Humana del Miembro Inferior: anatomia-del-miembro-inferior.pdf
Preguntas sobre las para ticas en laboratorio de Microbiología